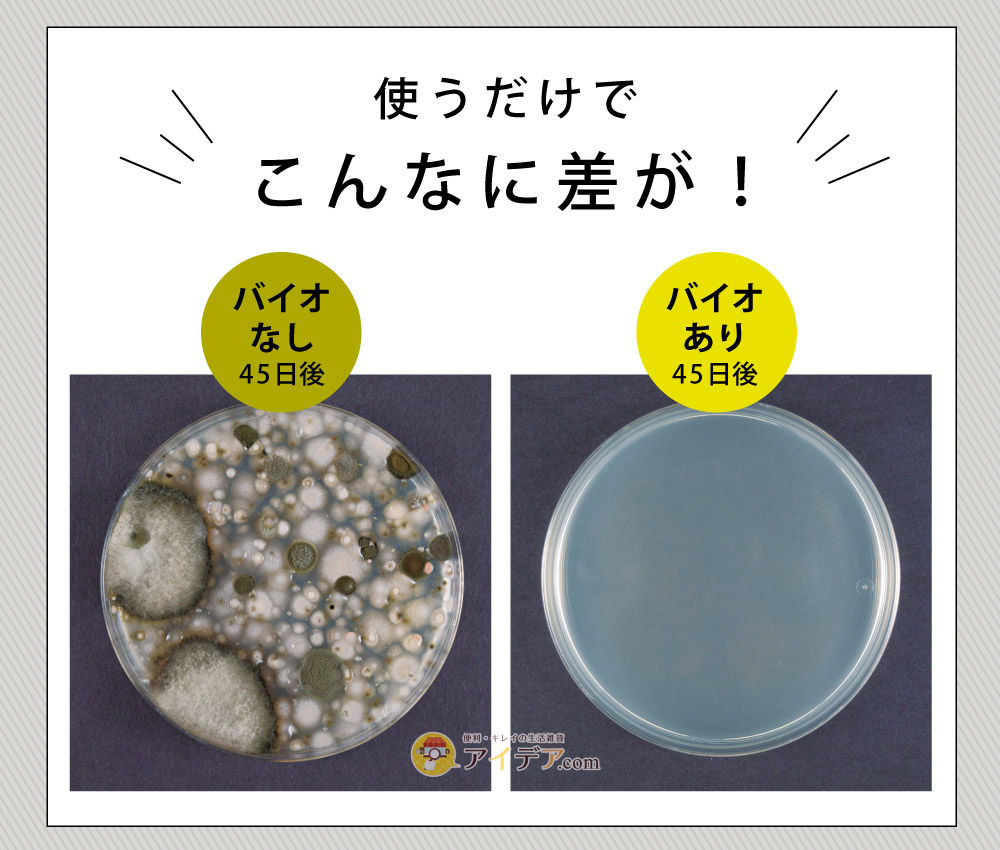

【希琳選物】日本Bio-洗衣槽防霉潔淨包
日本Bio-洗衣槽防霉潔淨包
【別用髒洗衣機洗衣服!看不見的霉菌交給它清光光】
請停止使用化學漂白水傷機器了! 來自日本銷售第一的 Power Bio 系列,推出了這款專為洗衣槽設計的「防霉潔淨包」。它利用微生物(Bio)與酵素的雙重力量,不僅能清除現有的霉菌,更能長效抑制再生,讓您的洗衣機從裡到外真正深呼吸。
✨ 四大亮點,打造良好潔淨洗衣環境
1. 微生物+酵素,雙效深入瓦解髒汙 與市售僅靠「氯系漂白水」短暫殺菌不同,這款產品含有5種黴菌(黑黴菌、麴黴菌、青黴菌、赤黴菌 (紅黴菌)、乾性麴黴菌)抑制菌。它利用「微生物」吃掉霉菌的養分,再配合「酵素」分解頑固汙垢與洗劑殘留。溫和卻強力,能有效去除洗衣槽背面那些刷不到的噁心黑垢。
2. 99.9% 抗菌消臭,衣服不再有悶味 經過實驗證實,能有效對抗 4 大惡臭源(氨氣、醋酸、三甲胺、硫化氫),徹底消除洗衣槽內特有的潮濕霉味。讓您洗出來的衣服,只留下純淨的清香。
3. 不含氯,安心不殘留 成分天然,不含刺鼻的氯系漂白劑,不會腐蝕洗衣機金屬內槽,也不用擔心化學殘留會傷害寶寶或敏感肌膚的家人。全自動洗衣機、滾筒式洗衣機皆可安心使用。
4. 效力長達 3 個月,持續守護 一盒內含 3 包,使用一次(1包)即可維持約 45 天的潔淨環境(視使用頻率而定)。定期使用,就能在洗衣槽內形成一層微生物防護網,讓霉菌無處可逃。
💡 適用情況
> 衣服越洗越臭:晾乾後仍有異味。
> 發現黑色海苔狀髒汙:洗衣槽太久沒洗,積滿汙垢。
> 家有嬰幼兒/敏感肌:拒絕使用化學清潔劑。
> 注重保養:希望延長洗衣機壽命。
📝 超簡單!三步驟使用教學
1. 【投入】:將 1 包粉末直接倒入洗衣機內槽(請勿放入洗劑投入口)。
2. 【運轉】:注入高水位(建議使用溫水效果更佳),運轉約 15 分鐘讓粉末溶解。
3. 【放置】:關閉電源,靜置浸泡約 2~4 小時(若髒汙嚴重可延長時間)。之後再依照一般洗衣程序(洗滌→清洗→脫水)運轉一次即可。
(※小撇步:第一次使用後若浮出大量髒汙,建議再用清水空洗一次,將浮出的霉垢徹底沖走。)
註: 本商品進口數量有限,若已售完,且可同意等到貨後再寄貨,那請選擇預購方式訂購,約9~14天即可收到(主要是看當下貨運公司狀況)。若有其他疑慮,還請透過官方line@與我們聯繫,謝謝。